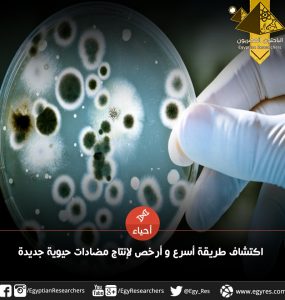

انتقل أسلافنا الأوائل منذ ملايين السنين من نظام غذائي قائم على الأشجار والشجيرات الصغيرة إلى البحث عن الطعام على الأرض. وقد أحدث هذا كل الاختلاف في تطور الإنسان. شَكَّـل التحول تجاه النظام الغذائي المُعتمِد على الأعشاب...
التصنيف - علم الأحياء التطوري
علم الأحياء التطوري هو حقل متعدد التخصصات، لأنها تضم عدد كبير من العلماء الآتين من التخصصات النظرية والعملية. فعلى سبيل المثال، هناك علماء متخصصين في دراسة مجموعة محددة من المتعضيات مثل علم الثدييات، أو علم الطيور، أو علم الزواحف والبرمائيات، لكنهم يستعملون هذه التعضيات كدراسات حالية للإجابة على الأسئلة العامة في نظرية التطور. وهناك أيضًا علماء الإحاثة والجيولوجيين الذين يستعملون المستحثات للإجابة عن الأسئلة التي تدور حول سرعة ونمط التطور، بالإضافة إلى النظريين الموجودين في علم وراثة السكان وفي علم النفس التطوري.